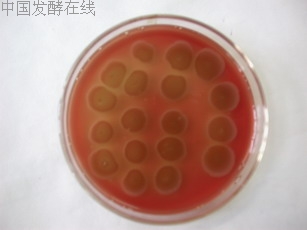
�鿴���ྫ��ͼƬ
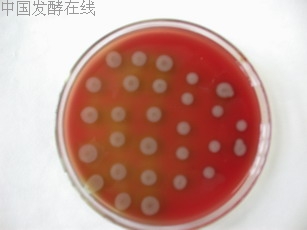
�鿴���ྫ��ͼƬ
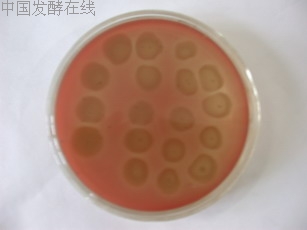
�鿴���ྫ��ͼƬ

生物表面活性剂发酵条件的优化、提取与分析
2007-08-05 12:40:39 来源:本站原创 评论:0 点击:
Abstract:Biosurfactant is a high surface-active agent synthesized by microorganism. Compared with themical surfactant, biosurfactant has a low toxicity to ecological system of Earth. The applications of biosurfactants in some fields such as enhanced oil recovery, energy industry, pharmaceuticals and cosmetics, food and environmental control are presented. This review is made from several aspects: screening of biosurfactant-producing microorganism, optimization of culture brooth, isolation of biosurfactant. Microorganisms capable of producing biosurfactants can be isolated by a series of steps including hydrocarbon enrichment culture, hemolytic activity assay on blood agar plates and oil displacement activity assay etc. the strains were isolated from waste soil and waste water. We screen one strain of bacteria and two strains of yeasts.
Keywords: Biosurfactant, screening, fermentation, optimization, isolation
1 引言
1.1 生物表面活性剂的概述
概述生物表面活性剂的产生、分类、特点以及应用。
1.2 生物表面活性剂的生产
微生物制备生物表面活性剂基本上还是可以主要分为培养发酵、分离提取、产品纯化三大步骤[17]。产生生物表面活性剂的微生物大多数生长在油含量较高的地方,可在富油环境下筛选出。生物表面活性剂的发酵条件,生产技术的改善已使生物表面活性剂的生产效率和使用效率有了很大的提高,应对经济可行性为方向进行研究。开发出简单高效的生物表面活性剂提取技术,降低生产成本也是使生物表面活性剂得到普及的重要因素,在目前的工业技术上还是有一定的难度。
1.3 生物表面活性剂的发展前景
无论在应用上,还是在环保上,生物表面活性剂的所有特性均超过了化工合成的表面活性剂。可以相信,生物表面活性剂的生产一定可以得到普及,并且在很快的时间内,可以超过化工合成的表面活性剂,而且最后完全取而代之。
2 试验器材和方法
2.1 试验菌种
试验菌种为不同种类的细菌,酵母和霉菌,均来自所采集的废水,污泥中。以下列出的为废水,污泥出处:a XX化工炼油厂;b XX四季青废水处理厂。
2.2 试验药品和试验仪器
2.2.1 试验药品
2.2.2 培养基配方
(1) 富集培养基:a 细菌富集培养基,正己烷在临用时无菌操作加入;b 酵母和霉菌富集培养基,正己烷在临用时无菌操作加入。(2)血平板培养基:羊血随用随加,不能进行灭菌。(3) 斜面培养基(4) 鉴别培养基:a 酵母鉴别培养基(Czapek培养基);b 霉菌鉴别培养基(Martin琼脂培养基),临用前加入0.03%链霉稀释液100ml,使每毫升培养基中含链霉素30µg。
2.2.3 试验器材和设备
2.3 试验原理与方法
2.3.1菌种的筛选
(1)菌种的来源与培养
产生生物表面活性剂的微生物一般是在富油条件下生长的,可以在一般城市的化工厂的排出废水中或是处理民用的污水处理厂里获得这些菌种。对其进行细菌和酵母还有霉菌富集培养。
(2) 菌种的选择
通过菌种是否具有溶血性来判断该菌种是否可以产生生物表面活性剂。因为产生生物表面活性剂的菌种有很强的抗菌溶菌作用,它可以将血琼脂平板上的血细胞水解,使菌落的周围产生明显的透明环。方法是:将菌种划线接种至血平板上,培养后若长出具有溶血现象的菌落,即为可能产生生物表面活性剂的菌种[20]。对其进行扩培纯化。
(3)优良菌株的筛选
比较它们之间的表面张力,可以通过比较发酵液的排油直径来得到结论。原理是:排油直径的大小与产物的含量和活性成正比。排油直径测定的方法是:取一培养皿,加水,水面上加0.1ml正烷烃形成油膜。在油膜中心加去杂发酵液(去杂方法见产物的提取),中心油膜被挤向四周形成一圆圈。圆圈直径大于3cm的菌株保留作进一步的研究[20]。
(4)镜检
a 细菌的镜检:采用Gram氏染色法。b 真菌的镜检:使用活体染色法。
2.3.2 发酵条件的优化
具体方法如下:采用单因素的优化的方法,分别对发酵液的碳源,氮源,初始PH,溶氧量,微量元素的种类进行替换,通过比较产物间的表面张力来得出最佳配方[18,21]。表面张力的测定即测定排油直径,最后选取排油直径最大的条件定为最优的发酵条件。
(1)分别用不同的碳源来代替正己烷来制备发酵液:玉米浆,葡萄糖,以及植物油。
(2)分别用不同的氮源来制备发酵液:蛋白胨,牛肉膏以及尿素。
(3)分别采用为5.0,6.0,7.0,8.0和9.0的初始pH值进行发酵培养。
(4)不同的转速对溶氧量进行控制,分别采取用160r/min,120r/min以及无振摇的温箱培养作为对比。
(5)采用不同的发酵温度来进行摇床发酵培养进行对比。选用28℃和37℃。
2.3.3 产物的提取
(1)发酵液除杂。发酵液进行离心,转速6000r/min,两次,取上清液,加入丙酮,剂量为发酵液的3倍,摇匀,放置半小时,再进行离心,转速6000r/min,离心一次,取上清液,蒸去丙酮。
(2)对去杂发酵液进行萃取。采用V氯仿:V甲醇=2:1作为萃取剂,剂量为去杂离心液的3倍,萃取3次[20],每次静置12小时,取下清液。
(3)进行70℃水浴蒸去萃取剂,蒸干得产物。
(4)重量法称重。先称取蒸馏产物用烧杯的净重,然后称取烧杯加产物的重量,减去烧杯的重量,即为产物重量。
3 试验步骤
3.1 菌种的筛选
3.1.1 样品采集
表1 样品的出处
|
地点 |
出处 |
样品简称 |
样品初始形态 |
|
XX化工炼油厂 |
未处理工业 废水和废油混合物 |
化油前段 |
浮油状液体,粘度与水相似,淡黄色,温度接近体温 |
|
XX化工炼油厂 |
处理后的工业 废水和废油混合物 |
化油后段 |
浮油状液体,粘度与水相似,淡黄色,温度低于体温 |
|
XX化工炼油厂 |
经过油水分离的排出废水 |
化油废水 |
泥水混合物,沉淀后取上液,混浊,色微黑 |
|
四季青污水处理厂 |
B段曝气池中的废水 |
污水B段 |
泥水混合物,沉淀后取上液,混浊,色棕色 |
|
四季青污水处理厂 |
废水处理池沉淀排出的污泥 |
污水污泥 |
黑色污泥,有恶臭味 |
3.1.2 菌种的富集培养
制备样品菌悬液。将10-4和10-6的稀释液分别投入菌富集培养基和酵母霉菌富基培养基。在28℃下振荡培养5天,摇床转速为160r/min。
3.1.3 筛选菌种
(1)制备菌悬液
(2)血平板涂布
血平板上进行划线。在28℃下培养2天。发现在部分菌落的周围出现了明显的溶血现象。在表2中为样本的溶血情况:
表2 初始富集培养菌种的溶血情况
|
样品出处 |
细菌富集性培养基 |
酵母霉菌富集性培养基 |
|
化油前段 |
有 |
有 |
|
化油后段 |
有 |
有 |
|
化油废水 |
有 |
无 |
|
污水B段 |
有 |
有 |
|
污水污泥 |
无 |
有 |
在表2中有溶血现象的平板上的菌落,挑取其中的菌继续进行血平板划线,直至出现有明显溶血现象的单菌落。在反复平板涂布后,菌落的溶血现象也各有不同,具体见表3。
表3 最终平板涂布溶血情况
|
样品出处 |
细菌富集性培养基 |
酵母霉菌富集性培养基 |
|
化油前段 |
明显 |
微弱 |
|
化油后段 |
微弱 |
明显 |
|
化油废水 |
明显 |
— |
|
污水B段 |
微弱 |
明显 |
|
污水污泥 |
— |
明显 |
下面各图为现象明显的血平板。见图1至图3。
图1 污水B段酵母霉菌富集性培养(正面)
图2 化油废水细菌富集性培养(正面)
图3 化油后段酵母霉菌富集性培养(背面)
(3)菌种产物活性测定
a.发酵培养:培养条件在摇床中28℃下振荡培养70小时,转速为160r/min。b.发酵液去杂c.测排油直径:测定4次。表4中为测定结果。d.决定菌种,由表4的结果,排油圈达到3cm以上的菌株代入到下面的试验中。
表4 筛选菌种中的排油直径测定结果
|
所属培养基 |
菌种来源 |
排油直径/cm |
平均排油直径/cm | |||
|
1 |
2 |
3 |
4 | |||
|
细菌富集性培养基 |
化油前段 |
2.8 |
2.6 |
2.6 |
2.7 |
2.7 |
|
化油废水 |
4.2 |
3.7 |
4.0 |
3.8 |
3.9 | |
|
酵母霉菌富集性培养基 |
化油后段 |
5.0 |
4.8 |
4.9 |
5.0 |
4.9 |
|
污水B段 |
4.1 |
4.2 |
4.4 |
4.0 |
4.2 | |
|
污泥 |
1.7 |
1.8 |
2.1 |
2.2 |
1.9 | |
为了显示出发酵液的排油效果,所以我们采用对发酵液进行染色的方法,然后将正烷烃用香柏油代替,可以看到明显的排油圈。见图4。
图4 排油直径效果图
图中的红点为染色剂(番红),黄色的光圈即为排油圈。此图仅为效果图,不作为菌种筛选的依据。
(4)菌种扩培
将接入斜面培养基进行扩培。同时做涂片检查,检查菌种是否已纯化。在28℃下培养2天。
(5)鉴别菌种
a 鉴别霉菌和酵母菌。鉴别对象:化油后段在酵母霉菌富集性培养基中以及污水B段在酵母霉菌富集性培养基中所分别长出的菌株。鉴别结果:两种菌株都在酵母鉴别培养基中长出,在霉菌鉴别培养基中被抑制。所以,可知化油后段和污水B段被筛选出的菌株都为酵母菌,对其进行镜检,见图5,图6。
b 鉴别细菌。用Gram氏染色法,进行镜检。鉴别出其为革兰氏阴性菌,形状为球状,无芽孢。见图7。
3.2发酵条件优化
选择了在表4中效果最明显的来自于化油后段的酵母菌作为发酵优化的试验菌株。采用酵母霉菌富集培养基作为基本发酵液。
3.2.1 碳源进行优化
分别用不同的碳源来代替正己烷来制备发酵液,大豆油和正烷烃取8ml,玉米浆和葡萄糖配成60g/l的溶液,取8ml。接种后放入摇床28℃下振荡培养70小时,转速为160r/min。测定去杂发酵液排油直径,结果见表5。
表5 不同碳源发酵液的排油直径
|
碳源 |
排油直径/cm |
平均排油直径/cm | |||
|
1 |
3 |
3 |
4 | ||
|
正烷烃 |
5.1 |
5.0 |
4.9 |
5.3 |
5.0 |
|
大豆油 |
4.4 |
4.8 |
5.0 |
5.3 |
4.8 |
|
玉米浆 |
5.5 |
5.5 |
5.6 |
5.3 |
5.5 |
|
葡萄糖 |
4.8 |
4.5 |
4.9 |
4.9 |
4.8 |
注:大豆油在离心过程中很难将油和发酵液分离干净,所以测定值可能有较大误差。
由此可见,由玉米浆作为碳源是比较合适的。
3.2.2 氮源的优化
分别用不同的氮源来制备发酵液,碳源用玉米浆,3种氮源取0.3%。接种后放入摇床28℃下振荡培养70小时,转速160r/min。测定排油直径,结果见表6。
表6 不同氮源发酵液的排油直径
|
氮源 |
排油直径/cm |
平均排油直径/cm | |||
|
1 |
3 |
3 |
4 | ||
|
蛋白胨 |
5.2 |
5.1 |
5.4 |
5.1 |
5.2 |
|
牛肉膏 |
5.2 |
5.1 |
5.1 |
5.0 |
5.1 |
|
尿素 |
5.6 |
5.5 |
54 |
5.5 |
5.5 |
由此可见,由尿素作为氮源是比较合适的。
3.2.3 初始pH值的优化
采用调节初始pH的方法来决定最佳的发酵初始pH值。摇床28℃下振荡培养70小时,转速为160r/min。测定排油直径,结果见表7。
表7 不同初始pH发酵液的排油直径
|
初始pH |
排油直径/cm |
平均排油直径/cm | |||
|
1 |
3 |
3 |
4 | ||
|
5.0 |
5.0 |
5.0 |
4.7 |
5.2 |
5.0 |
|
6.0 |
5.5 |
5.3 |
5.6 |
5.7 |
5.5 |
|
7.0 |
5.8 |
5.9 |
5.5 |
5.7 |
5.7 |
|
8.0 |
5.4 |
5.4 |
5.4 |
5.3 |
5.4 |
|
9.0 |
5.2 |
4.5 |
4.6 |
5.1 |
4.9 |
由此可见,在pH值为7.0左右时,比较适合于发酵培养。
3.2.4 溶氧量的对比
采用选出的最佳碳源,氮源以及初始pH。我们选用28℃摇床振荡培养70小时,转速为160r/min,120r/min以及无振摇的温箱培养作为对比。结果见表8。
表8 不同溶氧量发酵液的排油直径
|
摇床转速 |
排油直径/cm |
平均排油直径/cm | |||
|
1 |
3 |
3 |
4 | ||
|
160r/min |
5.8 |
5.8 |
5.6 |
5.8 |
5.8 |
|
120r/min |
5.6 |
5.7 |
5.4 |
5.4 |
5.6 |
|
0 |
4.4 |
4.5 |
4.7 |
4.6 |
4.5 |
由此可见,此种菌种耗氧量比较大。
3.2.5 发酵温度的对比
采用选出的最佳碳源,氮源及初始pH,但采用不同发酵温度来进行摇床发酵培养。选用28℃下和37℃下振荡培养70小时,转速为160r/min。结果见表9。
表9 发酵温度发酵液的排油直径
|
发酵温度 |
排油直径/cm |
平均排油直径/cm | |||
|
1 |
3 |
3 |
4 | ||
|
28℃ |
5.8 |
5.8 |
5.6 |
5.7 |
5.7 |
|
37℃ |
5.3 |
5.1 |
5.2 |
5.1 |
5.2 |
由此可见,体温显然不适合此种菌株的发酵。
3.2.6 发酵条件的优化结果
最优发酵条件为:硫酸铵0.6g,磷酸二氢钾0.3g,磷酸氢二钠0.2g,硫酸镁0.08g,硫酸亚铁0.001g,氯化钙0.01g,酵母膏0.05g,微量元素溶液0.5ml,玉米浆0.12g,尿素0.3%,蒸馏水100ml。初始pH值为7.0,发酵温度为28℃,振荡培养70小时,摇床转速为160r/min。
3.3 产物的提取
3.3.1 产物提取
用优化后的发酵条件进行发酵,得到的发酵液进行产物提取。实际进行5次萃取,每次的产量见表10。
表10 发酵液与产物关系
|
|
发酵液体积/ml |
去杂发酵液体积/ml |
产物外观 |
产量/g |
|
1 |
100 |
55 |
淡黄色晶体 |
0.1256 |
|
2 |
100 |
60 |
淡黄色晶体 |
0.0915 |
|
3 |
100 |
60 |
淡黄色晶体 |
0.0986 |
|
4 |
100 |
65 |
无色晶体 |
0.1112 |
|
5 |
100 |
60 |
淡黄色晶体 |
0.0875 |
根据上述结果,100ml发酵液的产量大约在0.1g左右,产物为淡黄色或无色晶体。
3.3.2 产物测定
(1)在发酵液进行产物提取之前,测定的发酵液排油直径,见表11。
表11 发酵液的排油直径
|
|
排油直径/cm |
平均排油直径/cm | |||
|
1 |
2 |
3 |
4 | ||
|
1 |
5.6 |
5.6 |
5.5 |
5.7 |
5.6 |
|
2 |
6.0 |
5.7 |
5.4 |
5.8 |
5.7 |
|
3 |
5.1 |
5.5 |
5.0 |
4.8 |
5.1 |
|
4 |
5.2 |
5.4 |
5.3 |
5.3 |
5.3 |
|
5 |
5.8 |
5.9 |
6.1 |
6.0 |
5.9 |
(2)将得到的5份产物重新加水溶解至100ml,测定排油直径,结果如表12。
表12 产物的排油直径
|
|
排油直径/cm |
平均排油直径/cm | |||
|
1 |
2 |
3 |
4 | ||
|
1 |
6.0 |
6.2 |
5.7 |
6.0 |
6.0 |
|
2 |
6.3 |
6.4 |
6.1 |
6.1 |
6.2 |
|
3 |
5.6 |
5.0 |
5.3 |
5.3 |
5.3 |
|
4 |
5.2 |
5.4 |
5.6 |
5.1 |
5.3 |
|
5 |
6.1 |
7.0 |
6.5 |
6.6 |
6.6 |
(3)由以上的两组数据比较可知,产物的确为生物表面活性剂。但是比较而言,重新溶解的产物比发酵液的活性高出不了很多。
(4)经薄层层析鉴定,该产物为糖脂。
结论
通过筛选,从5处样品中筛选出3株能表面活性较好的生物表面活性剂的菌株,其中1株细菌,2株酵母菌。对于其中效果最好的酵母菌进行发酵条件优化,通过对于酵母培养液的各种成分的进行调整,最后将可以测得的最大排油直径的发酵条件作为最优发酵条件。用优化后的发酵条件进行发酵培养,用萃取的方法提纯产物,最后得到晶体产物。
(1)产生生物表面活性剂的菌种的获取是十分容易的,在一般的城市中都可以得到。一般的实验条件下都可以进行菌种的筛选,这十分有利于应用到工业生产中去。
(2)生物表面活性剂的发酵条件的优化是要基于菌株的种类而定,不同的菌种对应于不同的发酵条件。本设计中,由于实验条件和时间所限,无法对于所得到的菌种进行下一步鉴定,所以只能使用针对普遍菌类的培养基进行配方上的修正来达到优化发酵条件的目的。但是对培养基的优化仅仅是针对于试验室研究,对于工业生产,应以实际出发,模拟大型发酵罐的实际条件来进行处理。
(3)生物表面活性剂的提纯,采用了最流行的萃取的方法,也采用了萃取生物表面活性剂最常用的甲醇和氯仿的混合液进行萃取。尽管氯仿/甲醇有较好的萃取效果,然而,在工业上,大量的使用氯仿作为萃取剂是不经济的。而且,氯仿是高毒性的含氯有机物,对环境、对人体都有害。所以在工业上不建议使用这种提取方法。但是相比较一些文献上的产率报道而言,本次课题的实际产率不是很高。而且无法分析纯度,所以试验只能停留在表面层次的产率上。目前还只能在实验室里进行小剂量的生产,无法应用到工业的大规模生产中,其中萃取的方法就是一个瓶颈,还有待于进一步提高技术,增加产量。
参考文献
1 孙炳寅,徐志伟,微生物产生的生物表面活性剂,生物技术,1994,4(4):1~6;
2 梅建风,王 普,生物表面活性剂,精细与专用化学品,2002(10):11~12;
3 夏咏梅,方 云,生物表面活性剂的开发和应用,日用化学工业,1999,2(1):27~31;
4 房秀敏,江 明,生物表面活性剂及其应用,现代化工,1996(6):17~20;
5 庄 毅,马梦瑞,生物技术与生物表面活性剂,山东化工,1994(1):20~26;
6 丁立孝,何国庆,孔 青等,微生物产生的生物表面活性剂及其应用研究,生物技术,2003,10(13):52~54;
7 范立梅,生物表面活性剂,生物学通报,2000(35):21~22;
8 Sarkar A K,Gours J.C.Sharma M M,et al. a critical evaluation of MEOR process[J].In Situ,1989,13:207~238;
9 张翠竹,,梁风来,张心平等,一种脂肽类生物表面活性剂的理化性质及其对原油的作用[J],油田化学,2000,7(2):172~174;
10 Rapp P,Bock H,Wager F et al. Use of tehalose lipids in enhanced oil recovery Biotechnol,1997,81:177~185;
11 Inoue,S,Kimwa Y,Kinta M et al. German Patent 2905252 to Kao Soap Co.. Japan,1979;
12 Inoue,S,Kimwa Y,Kinta M et al. German Patent 2905292 to Kao Soap Co.. Japan,1979;
13 White R T,Damm D,Miller J et al. Isolation and characterization of the human palmonary surfactant aporoteingene, Nature,1985,317:316~320;
14 Shephord R,Rockey J,Shutherland I W et al. Novel bioemulsifier from microorganisms for use in foods, J Biotechnol,1995,40:207~217;
15 Mulligan C N,Yong R N,Gibbs B F,Heavy metal removal from sediments by biosurfactants[J],Journal of Hazardous Materials,2001,85(1):111~125;
16 李祖义,杨勤萍,生物表面活性剂的合成,精细与专用化学品,2002(15):6~8;
17 Kuyukina M S,Ivshina I B,et al. Recovery of Rhodococcus biosurfactants using methyl tertiary-butyl ether extraction[J],Journal of Microbiological Methods,2001,46:149~156;
18 R.S. Makkar ,S.S. Cameotra,Appl Microbiol Biotechnol ,2002(58):428~434;
19 Kuyukina M S,Ivshina I B,Philp J C,Journal of Microbiological Methods,2001,46:149~156;
20 潘冰峰,徐国梁,施邑屏等,生物表面活性剂产生菌的筛选,微生物学报,1999,39(3):264~267;
21 李清心,康从宝,王 浩等,假单胞菌L-11产生生物表面活性剂发酵条件的优化,微生物学通报,2002,29(2):21~24。
上一篇:工业发酵染菌的防治
下一篇:气相色谱测定厌氧发酵气组分优化条件研究
评论排行
- ·中国发酵企业数据库(4)
- ·(4)
- ·CoQ10高产菌株选育的研究进展(2)
- ·抗生素发酵工艺所用冷却塔的性能分析及处理(1)
- ·微生物菌种选育技术.rar(1)
- ·发酵生产染菌及其防治(1)
- ·赤藓糖醇发酵工艺研究(1)
- ·重组AiiA 蛋白可溶性表达及发酵条件优化(1)
- ·生物反应器设计软件_发酵罐绿色版(1)
- ·酵母粉、酵母浸粉的区别(1)
- ·雷帕霉素研究进展(1)
- ·透明质酸用途和行业概况(1)
- ·黄酒制作工艺(1)
- ·水解(酸化)工艺与厌氧发酵的区别(1)
- ·糖蜜酒精废液处理过程中产生的微生物蛋...(1)
- ·紫杉醇高产菌发酵产物的分离、纯化和鉴定(1)





